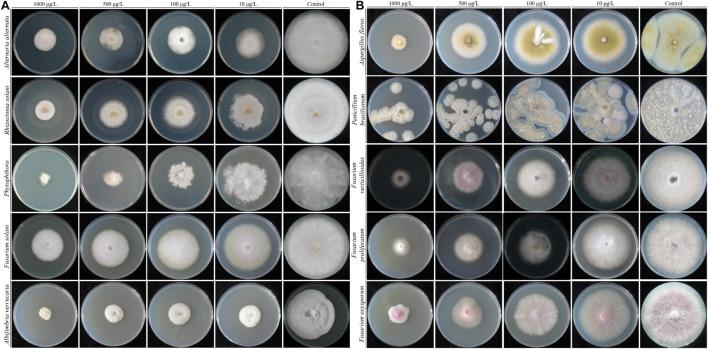

QSB-6的分离、鉴定及其抗菌机制及其对植物根系的影响
Isolation, Identification, and Antibacterial Mechanisms of QSB-6 and Its Effect on Plant Roots.
作者信息
Duan Yanan, Chen Ran, Zhang Rong, Jiang Weitao, Chen Xuesen, Yin Chengmiao, Mao Zhiquan
机构信息
National Key Laboratory of Crop Biology, College of Horticulture Science and Engineering, Shandong Agricultural University, Shandong, China.
出版信息
Front Microbiol. 2021 Sep 16;12:746799. doi: 10.3389/fmicb.2021.746799. eCollection 2021.
Apple replant disease (ARD) is a common problem in major apple planting areas, and biological factors play a leading role in its etiology. Here, we isolated the bacterial strain QSB-6 from the rhizosphere soil of healthy apple trees in a replanted orchard using the serial dilution method. Strain QSB-6 was provisionally identified as based on its morphology, physiological and biochemical characteristics, carbon source utilization, and chemical sensitivity. Maximum likelihood analysis based on four gene sequences [16S ribosomal RNA gene (16S rDNA), DNA gyrase subunit A (gyrA), DNA gyrase subunit B (gyrB), and RNA polymerase subunit B (rpoB)] from QSB-6 and other strains indicated that it had 100% homology with , thereby confirming its identification. Flat standoff tests showed that strain QSB-6 had a strong inhibitory effect on , , , , , , sp., , , , and , and it had broad-spectrum antibacterial characteristics. Extracellular metabolites from strain QSB-6 showed a strong inhibitory effect on hyphal growth and spore germination, causing irregular swelling, atrophy, rupture, and cytoplasmic leakage of fungal hyphae. Analysis of its metabolites showed that 1,2-benzenedicarboxylic acid and benzeneacetic acid, 3- hydroxy-, methyl ester had good inhibitory effects on , and increased the length of primary roots and the number of lateral roots of plantlet. Pot experiments demonstrated that a QSB-6 bacterial fertilizer treatment (T2) significantly improved the growth of Rehd. seedlings. It increased root length, surface area, tips, and forks, respiration rate, protective enzyme activities, and the number of soil bacteria while reducing the number of soil fungi. Fermentation broth from strain QSB-6 effectively prevented root damage from . terminal restriction fragment length polymorphism (T-RFLP) and quantitative PCR (qPCR) assays showed that the T2 treatment significantly reduced the abundance of in the soil and altered the soil fungal community structure. In summary, QSB-6 has a good inhibitory effect on in the soil and can significantly promote plant root growth. It has great potential as a biological control agent against ARD.
苹果再植病(ARD)是主要苹果种植区的常见问题,生物因素在其病因中起主导作用。在此,我们采用系列稀释法从重植果园中健康苹果树根际土壤中分离出细菌菌株QSB-6。基于其形态、生理生化特性、碳源利用和化学敏感性,菌株QSB-6被初步鉴定。基于QSB-6和其他菌株的四个基因序列[16S核糖体RNA基因(16S rDNA)、DNA促旋酶亚基A(gyrA)、DNA促旋酶亚基B(gyrB)和RNA聚合酶亚基B(rpoB)]进行的最大似然分析表明,它与[具体菌株名称未给出]具有100%的同源性,从而确认了其鉴定结果。平板对峙试验表明,菌株QSB-6对[多种病原菌名称未给出]具有较强的抑制作用,具有广谱抗菌特性。菌株QSB-6的胞外代谢产物对[某种真菌名称未给出]的菌丝生长和孢子萌发具有较强的抑制作用,导致真菌菌丝出现不规则肿胀、萎缩、破裂和细胞质泄漏。对其代谢产物的分析表明,1,2-苯二甲酸和3-羟基苯乙酸甲酯对[某种真菌名称未给出]具有良好的抑制作用,并增加了[某种植物名称未给出]幼苗的主根长度和侧根数量。盆栽试验表明,QSB-6菌肥处理(T2)显著促进了山定子(Malus baccata (L.) Borkh.)幼苗的生长。它增加了根长、表面积、根尖和根叉数量、呼吸速率、保护酶活性以及土壤细菌数量,同时减少了土壤真菌数量。菌株QSB-6的发酵液有效预防了[某种病原菌名称未给出]对根系的损害。末端限制性片段长度多态性(T-RFLP)和定量PCR(qPCR)分析表明,T2处理显著降低了土壤中[某种病原菌名称未给出]的丰度,并改变了土壤真菌群落结构。综上所述,QSB-6对土壤中的[某种病原菌名称未给出]具有良好的抑制作用,能显著促进植物根系生长。它作为一种防治苹果再植病的生物防治剂具有巨大潜力。